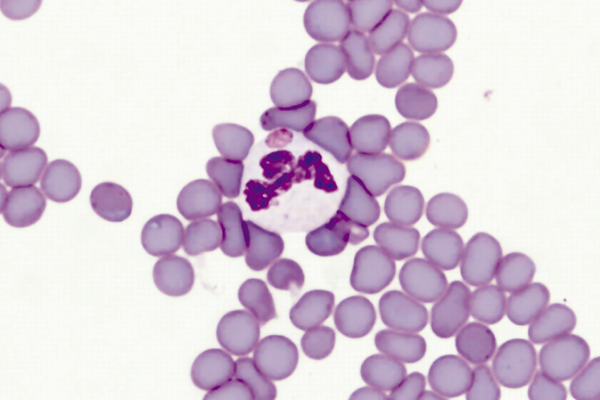

Анаплазмоз
Что такое анаплазмоз?
Анаплазмоз (Anaplasmosis) — трансмиссивное сезонное заболевание крупного и мелкого рогатого скота, протекающее с признаками анемии, лихорадки и истощения, вызываемая мелкими паразитами крови из рода Anaplasma. Болеют также северные олени и дикие жвачные.
Что вызывает анаплазмоз?
Анаплазмоз – широко распространенный гемоспоридиоз, вызываемый простейшими, относящимися к царству Protista, роду Anaplasma (Rickettsia). К А. marginale восприимчивы крупный рогатый скот, лоси, олени, козы, овцы и буйволы; A. ovis вызывает заболевание у овец, коз, архаров, сайгаков, муфлонов и других. Возбудителей анаплазмоза обнаруживают в основном в эритроцитах, но она также могут быть в лейкоцитах и тромбоцитах. Расположены в эритроцитах преимущественно на периферии, иногда ближе к центру. В одном эритроците может быть от одного до четырех возбудителей. Паразитемия составляет 3.40 %, в отдельных случаях может достигать 80 %.
При электронной микроскопии было установлено, что у анаплазм отсутствуют цитоплазма и ядро. Также были выявлены так называемые инициальные тельца, или микроколонии. Это округлые или овальные образования, покрытые тонкой мембраной. Кроме того, сама микроколония окружена двуслойной плазменной мембраной, содержимое которой имеет вид гранулированной, лентовидной или кольцевидно-трубчатой структуры
Кто является переносчиком заболевания, а кто - источником инвазии?
Источником инвазии являются животные-анаплазмоносители. Переносчиками возбудителя являются иксодовые и аргасовые клещи, а также кровососущие насекомые (слепни, комары, мошки, мокрецы, мухи-жигалки, овечьи кровососки и др.). Анаплазмоз распространен практически повсеместно; заболевание, как правило, регистрируют весной, летом и осенью. Однако при плохих условиях содержания и кормления, а также из-за нарушения правил асептики и антисептики при проведении ветеринарно-зоотехнических манипуляций возможны случаи заболевания животных и зимой. Очень часто анаплазмоз протекает в виде смешанной инвазии с пироплазмидозами. Также существует риск заражения анаплазмозом при использовании не стерильных инструментов забора крови для здоровых и зараженных животных.

Какие существуют клинические симптомы анаплазмоза?
Продолжительность инкубационного периода зависит от способа заражения и степени паразитемии и составляет от 10 до 175 суток, в среднем 1-2 месяца. Болезнь протекает остро и хронически.
- При остром течении резко повышается температура тела (до 41 °С), ухудшается общее состояние, аппетит отсутствует. У животных наблюдают резко выраженную анемию, желтушность слизистых оболочек. Увеличиваются лимфоузлы. Ухудшается деятельность сердечно-сосудистой системы и органов дыхания. Развивается атония преджелудков. Животные быстро худеют. Развиваются отеки в области подгрудка. Моча на протяжении болезни остается прозрачной.
- При хроническом течении отмечают перемежающуюся лихорадку. Животные худеют, быстро устают при перегонах. Наблюдается гипотония желудочно-кишечного тракта. Уменьшается число эритроцитов, снижается содержание гемоглобина. Слизистые оболочки остаются бледными. При исследовании крови вначале выявляют лейкоцитоз, затем лейкопению, резкое уменьшение количества эритроцитов и гемоглобина, анизоцитоз, пойкилоци-тоз, базофильную зернистость эритроцитов, значительное поражение эритроцитов анаплазмами (до 30.40 %, иногда и более). Часто наблюдают рецидивы.
- Выздоровление наступает медленно, молодняк резко задерживается в развитии. После переболевания, как правило, животное остается длительное время аноплазмоносителем. Смертность иногда достигает 30-40 %
- При анаплазмозе развивается нестерильный иммунитет (премуниция), который поддерживается присутствием анаплазм в крови переболевших животных. В формировании иммунитета участвуют клеточно-зависимые факторы: Т- и В-лимфоциты, макрофаги. Наличие и возрастание количества анаплазм в организме животных вызывают выработку специфических иммуноглобулинов — антител, а также аутоантител, которые способствуют изъятию из крови пораженных анаплазмами эритроцитов и утилизации их в макрофагах, клетках РЭС. Если организм переболевшего животного полностью освободить от анаплазм. то через 3.4 месяца состояние невосприимчивости утрачивается

На основании чего ставится диагноз?
При постановке диагноза учитывают эпизоотическую ситуацию, клиническое проявление, а также исследуют мазки крови, окрашенные по Романовскому. Разработаны серологические методы диагностики. Дифференцируют анаплазмоз от лептоспироза и пироплазмоза.
Как лечат анаплазмоз?
Для лечения анаплазмоза было предложено более 200 препаратов, но выраженным лечебным эффектом обладают лишь препараты тетрациклинового ряда, что подчёркивает необходимость поиска специфических лекарственных средств. Подход к лечению должен быть комплексным и включать в себя патогенетическую и симптоматическую терапию, направленную на восстановление функции кроветворения, нормализацию работы пищеварительного тракта.
Для восстановления нормальной деятельности пищеварительного тракта животным скармливают свежие, зелёные, доброкачественные корма, болтушку из овсяных отрубей, молоко.
Какие разработаны меры профилактики анаплазмоза?
Как и со всеми заболеваниями, переносчиками которых являются кровососущие насекомые, меры профилактики сводятся к предотвращанию заражения. Крупный и мелкий рогатый скот обрабатывают специальными препаратами от паразитов, проводят обработку животноводческих помещений. Животных обрабатывают первый раз за 5-7 дней до планируемого выгона на пастбища, затем в зависимости от препарата каждые 10-20 дней, до окончания пастбищного периода.
Необходимо учитывать ограничения и противопоказания к акарицидным препаратам: для дойных животных, больных, ослабленных или планируемых к убою.
При наличии большого количества кровососущих паразитов на пастбищных угодьях, необходимо вакцинировать поголовье животных. Необходимо использование вакцины против анаплазмоза, которая предохраняет животных от заболевания при введении заведомо инфицированной крови и нападении инвазированных клещей.

Список использованной литературы:
http://webmvc.com
http://pedagogy.ru
https://ru.wikipedia.org
https://ru.wikipedia.org
Written by
Arina TARAN
BreedsMore
IllnessesMore
Forage cropsMore
Патологическая физиология голодания Arina TARAN
Дефицит фосфора (гипофосфатемия) Hipofosfatemi Arina TARAN
Какие бывают кормораздатчики для ферм КРС? Irina Makarova
Кормушки для овец Diana Myakisheva
Питание домашних коз: что едят, виды корма и правила кормления Alina Arslantürk
Важность минералов питании сельскохозяйственных животных Irina Makarova

Что такое анаплазмоз?

















